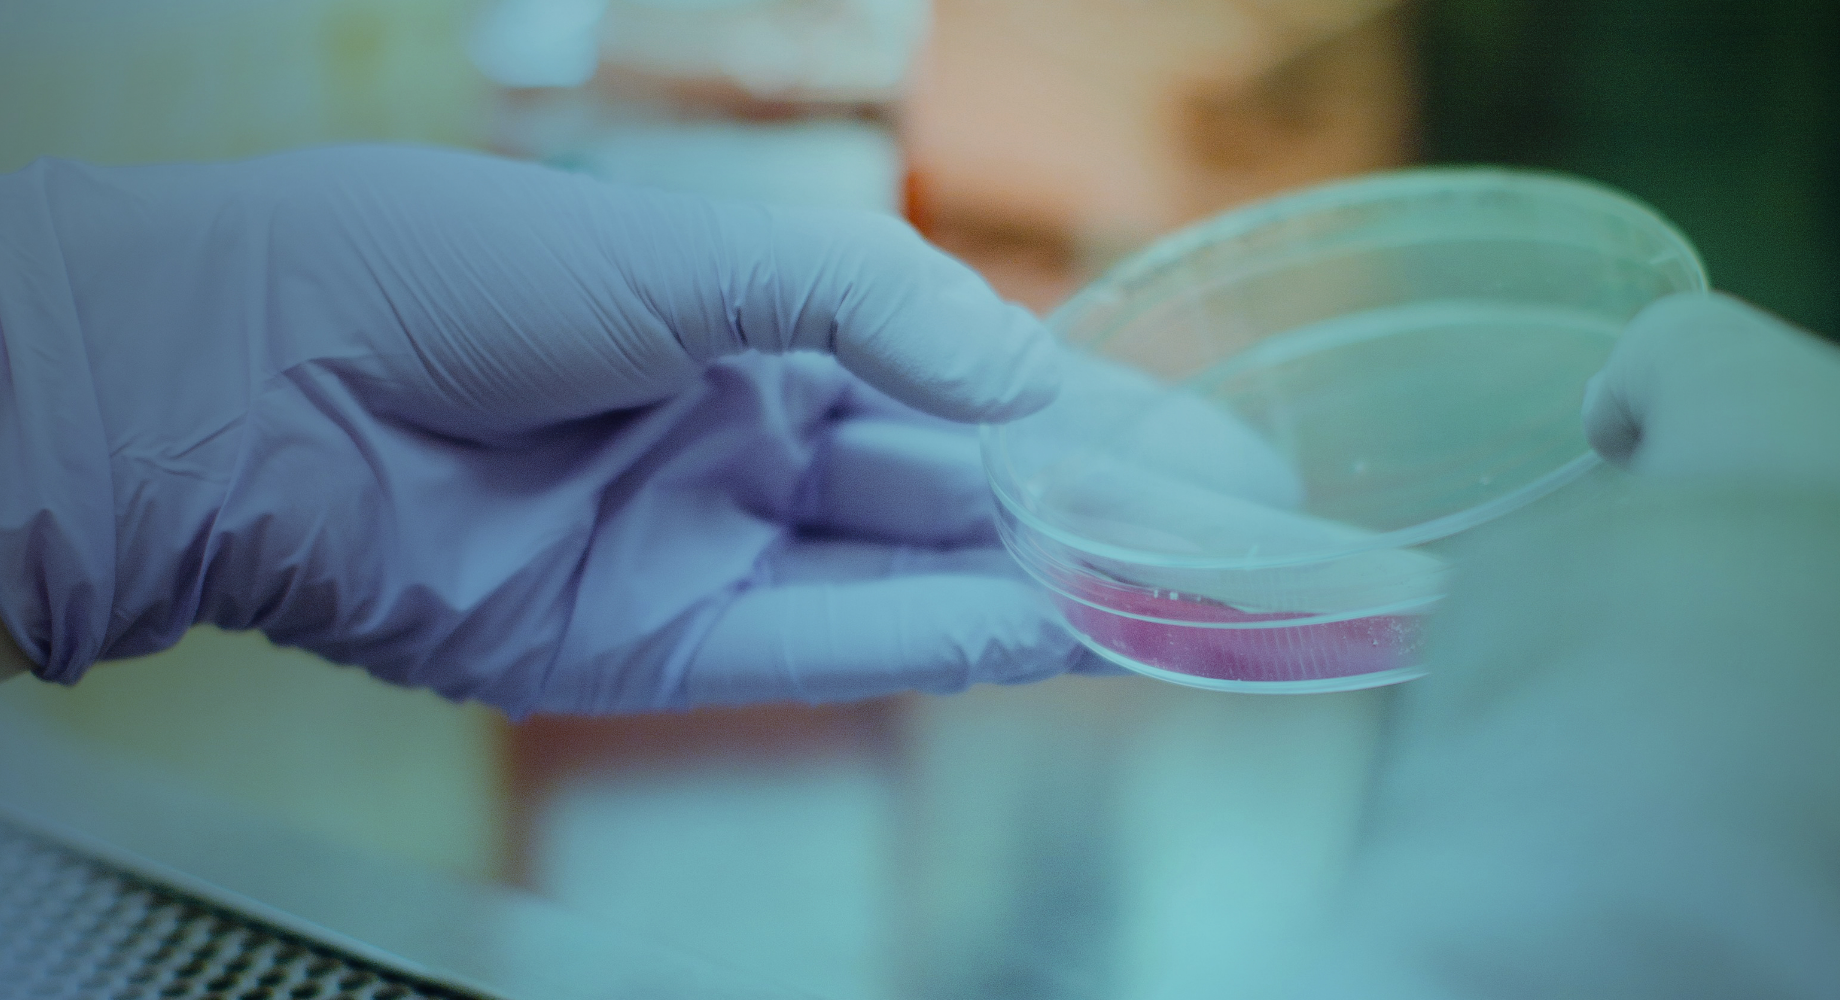
Prevent Pandemics - BG

Campaign for the Science Museum
Climateof Minnesota
Campaign for the Science Museum
We can’t wait for the future; we need to start now. As your Science Museum, we embrace our responsibility to equip catalysts of change with inspiration, knowledge and skills to answer some of the most pressing questions of our times — ultimately leading Minnesota boldly forward.

How can we adapt to our warming planet?
How can we prevent future pandemics?

How can we help more people see themselves in STEM careers?

How can we harness technology to expand our human potential?

How can we sustain healthier communities?
